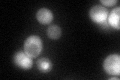
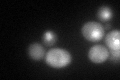

View description
Protein required for processing of 20S pre-rRNA in the cytoplasm, associates with pre-40S ribosomal particles
Localization:
Intensity:
Fold change:
Significance:
-
C’ GFP library in SD
nucleus:cytosol66.83 -
N' NOP1pr-GFP in SD

N/A0 -
N' TEF2pr-mCherry in SD

N/A0 -
N' NATIVEpr-GFP in SD

N/A0 -
N' TEF2pr-VC and Cyto-VN in SD

N/A0 -
C’ GFP library in SD+DTT
nucleus.cytosol46.390.69No -
C’ GFP library in SD+H2O2

nucleus.cytosol60.380.9No -
C’ GFP library in Starvation Media

nucleus,cytosol33.310.49Yes -
C’ GFP library on the background of Pup2-DaMP

nucleus:cytosol -
C’ GFP library on the background of CCT mutant

nucleus:cytosol77.47541.15909No
